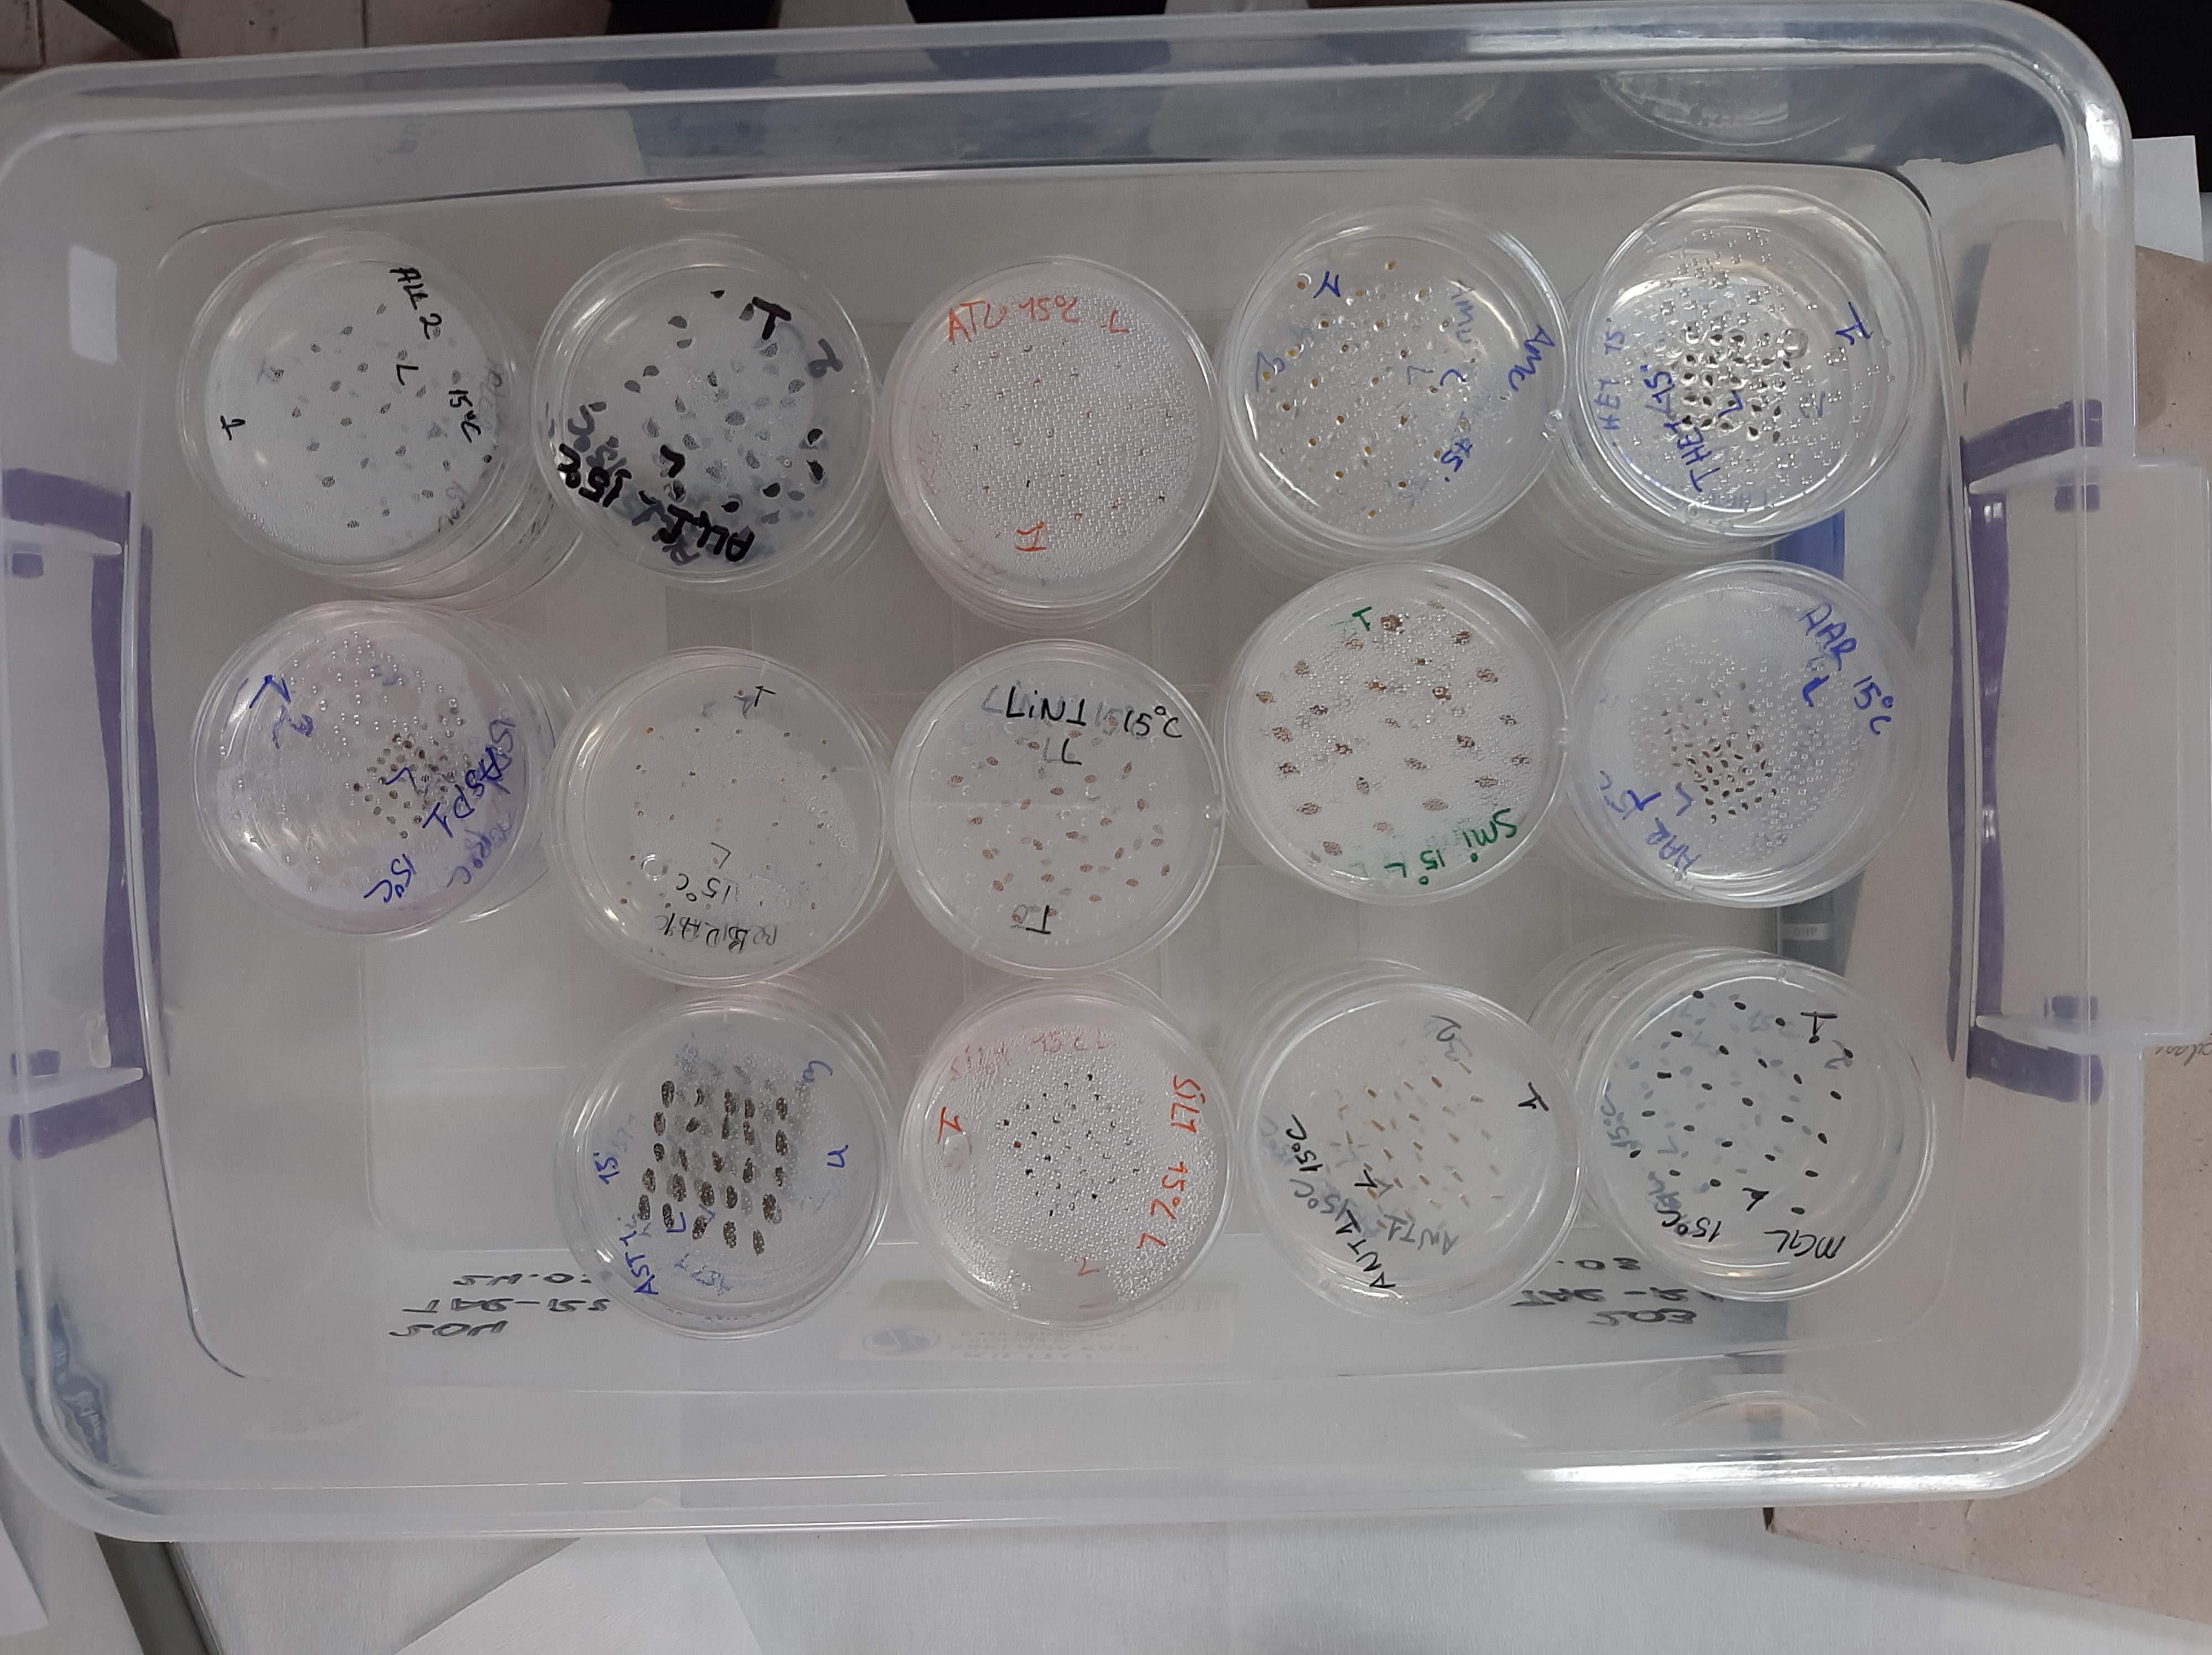

Research areas | Current Projects | Databases/Datasets | Previous projects
Current research in the Functional Ecology Lab focuses mainly on plant ecology and fire ecology. Using the trait-based ecological approach, we study the role of fire and climate in shaping functional traits of plant species, from population to biome levels. We are also interested in the responses of plants to climate change.
Ecological dynamics in the biodiversity-rich Anatolian peninsula is another research focus of our lab. We are conducting research projects on post-disturbance (e.g., fire) recovery of plant communities, plant-animal interactions (e.g., seed dispersal via mammals), and functional trait variability in plant species.
Fire Ecology
Fire is an important component of many ecosystems on Earth. We study the role of fire in shaping the ecology and evolution of plants and animals. While our experimental research on fire ecology primarily focuses on the Mediterranean and steppe ecosystems of Türkiye, we also collaborate with colleagues from other parts of the world to extend our research to other fire-prone regions.
We conduct research on the post-fire recovery of plant and animal communities, as well as fire-related plant traits such as post-fire germination and serotiny. Additionally, we investigate the underlying reasons behind current fire regimes. By analyzing these aspects of fire ecology, we aim to draw conceptual frameworks related to wildfire management and to improve our understanding of the role of fire in natural ecosystems.
To accomplish these goals, we collect data from field surveys and laboratory experiments. We also utilize modeling approaches to predict the future of fire regimes. Through these methods, we strive to enhance our understanding of the effects of fire on natural systems and to develop better strategies for managing fire in the wild.




.
Functional Ecology
Functional ecology is a field that investigates the role of organisms in ecosystems, with a focus on their functional traits and interactions with the environment. Its goal is to understand how an organism’s morphology, physiology, behavior, and life history affect its performance and contribute to its fitness and survival.
Within this context, we study how organisms and communities respond to climate and land-use changes, aiming to understand how specific traits shape their response to these changes and enable them to survive in different environmental conditions and habitats. To achieve this goal, we are documenting plant functional traits in Mediterranean and Anatolian steppe ecosystems by compiling data from literature, performing measurements, and conducting experiments. By doing so, we aim to understand the mechanisms underlying ecological processes and predict the effects of environmental changes on these ecosystems.
Our ultimate goal in studying functional ecology is to develop a mechanistic understanding of how species and ecosystems function. We aim to use this knowledge to inform conservation and management decisions, helping to ensure the long-term survival of these ecosystems and the species that inhabit them.



.
Climate Change Ecology
Climate change ecology is the study of how climate change, one of the most significant environmental problems of our time, affects the interactions between living organisms and their environment, and the implications for ecosystem structure and function.
Our primary focus in studying climate change is to understand its impacts on Mediterranean and Anatolian steppe ecosystems, with particular attention to the survival and fitness of plant species and the structure and composition of plant communities. To achieve this goal, we conduct laboratory and field experiments to observe the germination and seedling growth of natural Mediterranean and steppe species under predicted future conditions of enhanced temperatures, increased drought, and salinity stresses. Additionally, we use modeling approaches to understand the vegetation dynamics and potential species distributions under future climates.
Through our research, we aim to develop effective conservation strategies for biodiversity and to predict and mitigate the effects of climate change on natural ecosystems. By studying the impacts of climate change on species and communities in these ecosystems, we hope to contribute to the development of sustainable management practices that can help protect and preserve these ecosystems for future generations.
.
Germination Ecology
Seed germination and seedling establishment are crucial for the persistence and regeneration of plant populations, as well as for the functioning of ecosystems. Our research on fire ecology, climate change ecology, and functional ecology includes a general study of germination ecology.
In this context, we investigate the factors that affect seed germination and subsequent seedling establishment and survival in Mediterranean and Anatolian steppe ecosystems. Specifically, we explore the environmental cues that trigger germination, such as temperature, light, heat shock, smoke, and chemicals, as well as the relationships between germination and seed traits, such as seed mass and seed coat properties.
Our research helps to understand the germination patterns of several plant species in Anatolian ecosystems that have been overlooked in germination ecology and contributes to the development of effective management and conservation strategies for these species.

.
Animal Ecology
Plants and animals are interdependent in many ways, and we investigate this relationship through plant-animal interactions, such as zoochorous seed dispersal and pollination, as well as animal functional diversity. Our research explores how animals contribute to the functioning of ecosystems through these interactions and how changes in these interactions affect the structure and function of ecosystems.
By studying the ecological roles of animals, we aim to better understand the mechanisms underlying ecosystem processes and to inform conservation and management efforts. Specifically, we focus on Mediterranean ecosystems, temperate forests, and Anatolian steppes.
.